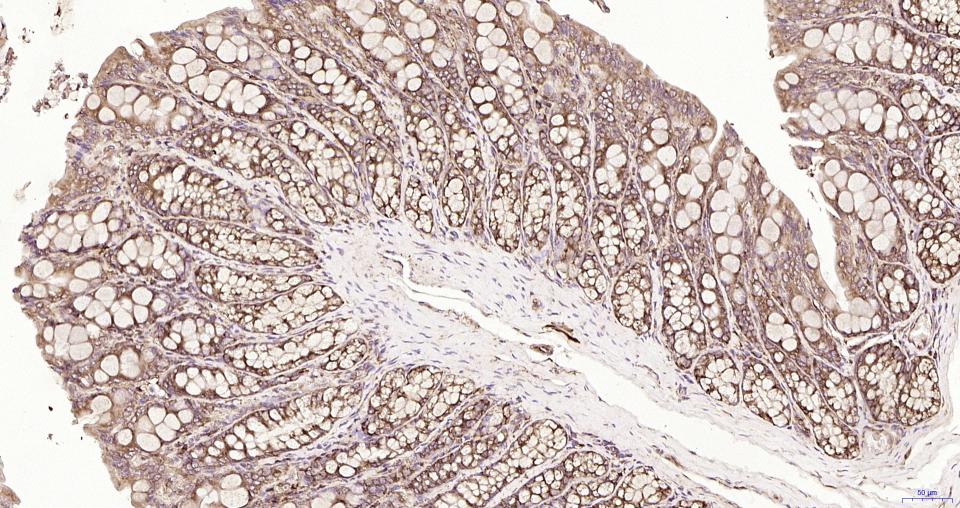
S19核糖体蛋白重组兔单抗
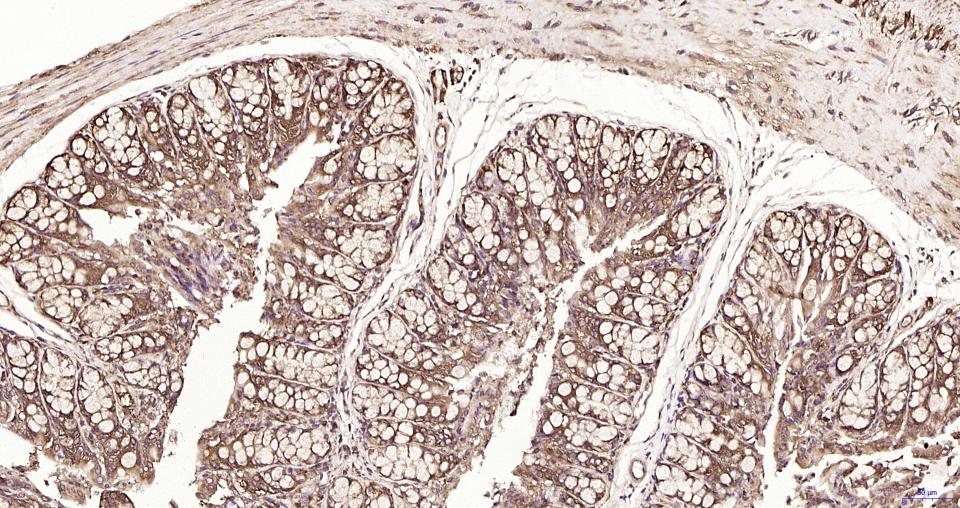
S19核糖体蛋白重组兔单抗

RPS19 Recombinant Rabbit mAb (一抗) | Bioss

概述
- entrezGene:6223
human - swissprot:P39019 human
Ribosomes, the organelles that catalyze protein synthesis, consist of a small 40S subunit and a large 60S subunit. Together these subunits are composed of 4 RNA species and approximately 80 structurally distinct proteins. This gene encodes a ribosomal protein that is a component of the 40S subunit. The protein belongs to the S19E family of ribosomal proteins. It is located in the cytoplasm. Mutations in this gene cause Diamond-Blackfan anemia (DBA), a constitutional erythroblastopenia characterized by absent or decreased erythroid precursors, in a subset of patients. This suggests a possible extra-ribosomal function for this gene in erythropoietic differentiation and proliferation, in addition to its ribosomal function. Higher expression levels of this gene in some primary colon carcinomas compared to matched normal colon tissues has been observed. As is typical for genes encoding ribosomal proteins, there are multiple processed pseudogenes of this gene dispersed through the genome. [provided by RefSeq, Jul 2008]

产品应用
| 应用 | 已检合格种属 | 预测种属 | 推荐稀释比例 |
|---|---|---|---|
| WB | Human, Mouse, Rat | 1:500-1000 | |
| IHC-P | Human, Mouse, Rat | 1:100-500 | |
| IHC-F | Human, Mouse, Rat | 1:100-500 | |
| IF | Human, Mouse, Rat | 1:100-500 | |
| IP | Human, Mouse, Rat | 1:20-50 |
交叉反应
交叉反应: Human, Mouse, Rat
相关产品
暂无相关产品
靶标
Higher level expression is seen in the colon carcinoma tissue than normal colon tissue.
Belongs to the eukaryotic ribosomal protein eS19 family.
Required for pre-rRNA processing and maturation of 40S ribosomal subunits.